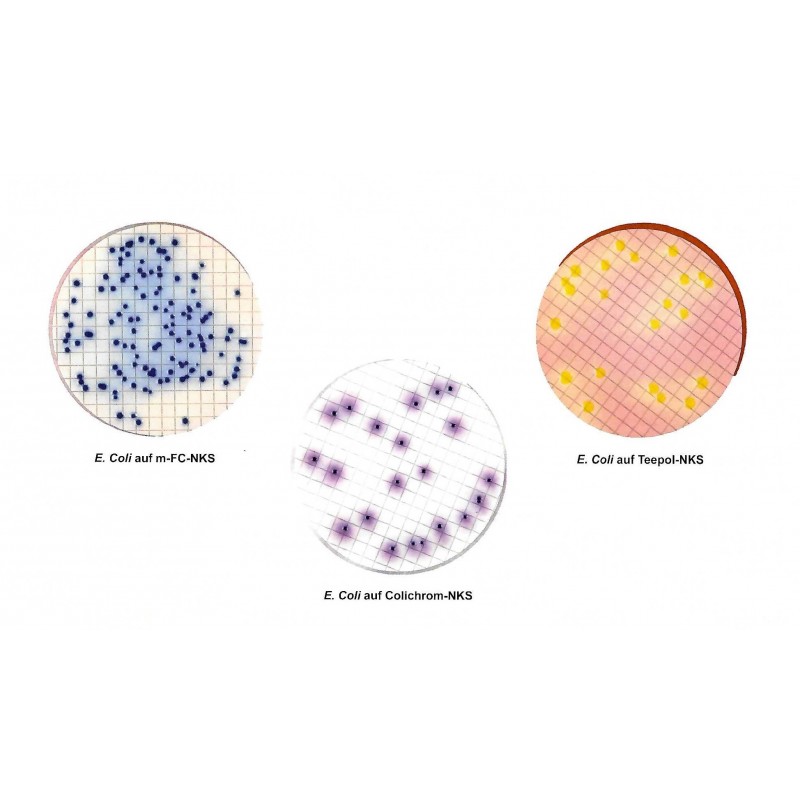

M-FC-NKS
1100
118,00 CHF
zzgl. MwSt.
verpackt zu 50Stk
Zum Nachweis von fäkalen, coliformen Keimen aus Abwasser und anderen Untersuchungsmaterialien.
1100
Technische Daten
- Nachweis
- Coliforme
E. coli - Verpackung
- 50 Stk